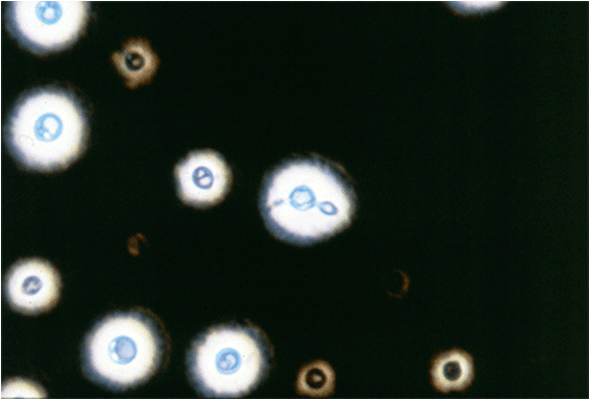
- India ink preparation of CSF sample

Early diagnosis of fungal infection is critical for effective treatment. Â For many decades, culture, direct microscopy, and histopathology have been the foundation for the diagnosis of fungal infections.
The severely immunosuppressed patient population is continuously growing not only because of longevity provided by advances in health care but also due to a growing population living with HIV/AIDS and people using immunosuppressive agents. These populations are susceptible to infection from fungi rarely seen, or never reported as a human pathogen. Â The growth in the number/diversity of fungi that clinical mycologists must identify has been growing ever since. It has forced investigators to develop and apply new methods for fungal identification that go beyond classical phenotypic methods. Currently, there is an increased emphasis on the use of more specific tests such as molecular diagnostics and antigen detection for the diagnosis of fungal infections.
Common approaches for the laboratory diagnosis of fungal infections are:
- Direct microscopic examination of clinical samples including histopathology
- Culture of the organism
- Antigen detection tests
- Serologic tests
- Molecular diagnostics (DNA probe tests)
Direct Microscopic Examination
| Method | Primary Use | Advantages | Disadvantages |
|---|---|---|---|
| Acid fast stain and partial acid fast stain | Detection of mycobacteria and Nocardia, respectively | Detects Nocardia and some isolates of B.dermatitidis | Tissue homogenates are difficult to observe because of background staining |
| Calcofluor white | Detection of fungi | Can be mixed with KOH: detects fungi rapidly because of bright fluorescence | Requires use of fluorescence microscope |
| Gram stain | Detection of bacteria | Will detect most fungi if present in that specimen | Some fungi stain weakly (e.g. Cryptococcus spp) |
| India Ink | Detection of Cryptococcus neoformans in CSF | If present, is diagnostic of cryptococcal meningitis | Positive in less than 50% of cases of meningitis, not sensitive in non-HIV meningitis |
| Potassium hydroxide (KOH) mount | Clearing of specimen to make fungi more readily visible | Rapid detection of fungal elements | Clearing of some specimen make take hours, experience required since background artifacts are often confusing |
| Methenamine silver stain | Detection of fungi in histologic section | Best stain to detect fungal elements | Requires a specialized staining method |
| Periodic acid-Schiff (PAS) stain | Detection of fungi | Stain fungal elements well; hyphae of molds and yeasts can be readily distinguished | |
| Wright stain | Examination of bone marrow or peripheral blood sample | Detects H.capsulatum and C. neoformans |
Direct microscopic examination of clinical specimens such as sputum, biopsy, CSF, and/or skin scrapings provides a rapid and accurate diagnosis of some fungal infections.
Diagnostic features of fungal pathogens, when stained by various dyes (e.g. asexual spores, hyphae etc), helps in the identification.
Traditionally, the potassium hydroxide preparation has been the recommended method for the direct microscopic examination of specimens (specimen is treated with 20% KOH to dissolve tissue material, leaving alkali-resistant fungi intact). However, now it is believed that calcofluor white stain is superior.
Culture of the organism
Culture from a clinical sample is the gold standard for the diagnosis of fungal infection. Culture has the advantage of yielding the specific etiological agent if positive. Moreover, culture allows for susceptibility testing.

Culture methods also do have significant limitations; primarily, it takes many days to obtain culture results which impairs prompt and effective treatment.  The sensitivity of the culture varies with diseases (e.g. blood culture may miss ≥50% of patients of disseminated candidiasis, recovery of Histoplasmacapsulatum from sputum of patients with active pulmonary histoplasmosis is only 10-15%). It is also complicated by the biosafety hazard associated with culture of the mycelial form/airborne conidia e.g. Coccidioides spp.
Fungi are frequently cultured on Sabouraud dextrose agar (SDA) which facilitates the appearance of the slow-growing fungi by inhibiting the growth of bacteria. Inhibition of bacterial growth is due to the low pH of the medium and use of antibiotics.
Colony characteristics of the isolate, and the nature of the asexual spores, mycelium are sometimes sufficient to identify the common pathogen but identification of less common fungi that may cause opportunistic infections requires a high level of expertise on the part of laboratory personnel.
Antigen Detection Test
Fungal polysaccharides or proteins may be shed into body fluids during the course of infection, which can be detected using specific antibodies.
In cryptococcal meningitis, the presence of polysaccharide capsular antigen (glucuronoxylomannan) of Cryptococcus neformans in the spinal fluid can be detected by the latex agglutination test.  In invasive aspergillosis polysaccharide antigen (galactomannan) present in the cell wall of most Aspergillusspp is detected.  Detection of polysaccharide antigen of Histoplasma capsulatum in body fluids, especially urine, has been useful in presumptive diagnosis of histoplasmosis in patients with disseminated disease. Immunoassays have also been developed for the detection of galactomannan from B. dermatitidis and C. immitis in urine and other body fluids.
Advantages and Limitations of antigen detection test
- As antigen can be shed from a local site of infection to a body fluid such as blood or urine, antigen detection tests help to avoid highly invasive sample collection. Circulating or urinary antigen functions as a surrogate for the actual presence of the pathogen.
- Antigen detection test methods are inexpensive, rapid and capable of use by personnel with limited training.
- Depending on the clinical needs, it is possible to produce a test with a broad or a very limited specificity by judicious use of antibodies.Â
- A major limitation of antigen testing is the need to identify antigen surrogates for infection.
Serologic Tests
Serology is of greatest value in the diagnosis of endemic mycoses. Tests for the presence of antibodies in the patient’s serum or spinal fluid are useful in diagnosing systemic mycoses but less so in diagnosing other fungal infections. As in the case of bacteriologic and viral serologic testing, a significant rise in the antibody titre must be observed to confirm a diagnosis. Available test methods include immunodiffusion (ID), complement fixation (CF), and enzyme immunoassay (EIA). Serologic methods are used for the diagnosis of coccidioidomycosis, histoplasmosis, and blastomycosis.
Advantages of use of serological testing for diagnosis of
invasive fungal infection:
- Results may be positive when culture results are negative or samples are difficult to obtain.
- If positive, serological results may reduce the need for culture of potentially hazardous fungi, for example, Coccidioides spp.
- Serology requires a minimally invasive sample, which lowers barriers to testing.
Disadvantages
- Low levels of sensitivity and specificity. A negative serologic test should not exclude the presence of fungal infection. Some tests, particularly complement fixation, are time-consuming and require trained personnel. Immunocompromised patients may show a reduced antibody response, reducing the value of serologic assays.
- Difficulty in Interpretation of serological results Inability of serology that measures IgGto distinguish between current or previous infection (detection ofIgMis useful indiagnosisof acute fungal infections). False positives may occur with some tests in the setting of other endemic fungal infections.
Molecular Diagnostics
Use of modern molecular tools for the identification of the fungal pathogen is rising rapidly. This advancement is driven by the rapid accumulation of protein and DNA sequence data and growing need to identify a broader range of fungi.
Molecular methods for fungal diagnosis can be broadly categorized into two subsets:
- Non-Culture-Based Molecular Diagnostic Methods
- Culture-Based Molecular Diagnostic Methods
If a template nucleic acid is available in patient specimens, a polymerase chain reaction (PCR) can be used to amplify the fungal DNA which can be detected using appropriate techniques. FilmArray Blood Culture Identification (BioFire Diagnostics, Inc.), which is a PCR-based reaction performed on positive blood cultures and detects mainly Candida spp is a FDA approved fungal identification method.
Tests involving DNA probes can identify colonies growing in culture at an earlier stage of growth than can tests based on visual detection of colonies. As a result, the diagnosis can be made more rapidly. At present, DNA probe tests are available for Coccidioides, Histoplasma, Blastomycesand Cryptococcus.
Proteomics Profiling/Fingerprinting
Matrix-Assisted Laser Desorption/Ionization Time-of-Flight (MALDI-TOF) is the most popular and fastest growing non-nucleic acid sequence based molecular diagnostic assay for fungi.
The technique generates species-specific spectra that provide a unique signature characteristic of the species. The technology has already been commercialized for microbial identification, with instruments being available from Bruker Daltronics (MALDI Biotyper), Andromas (Andromas), and bioMérieux (Vitek MS). Find more about MALDI-TOF